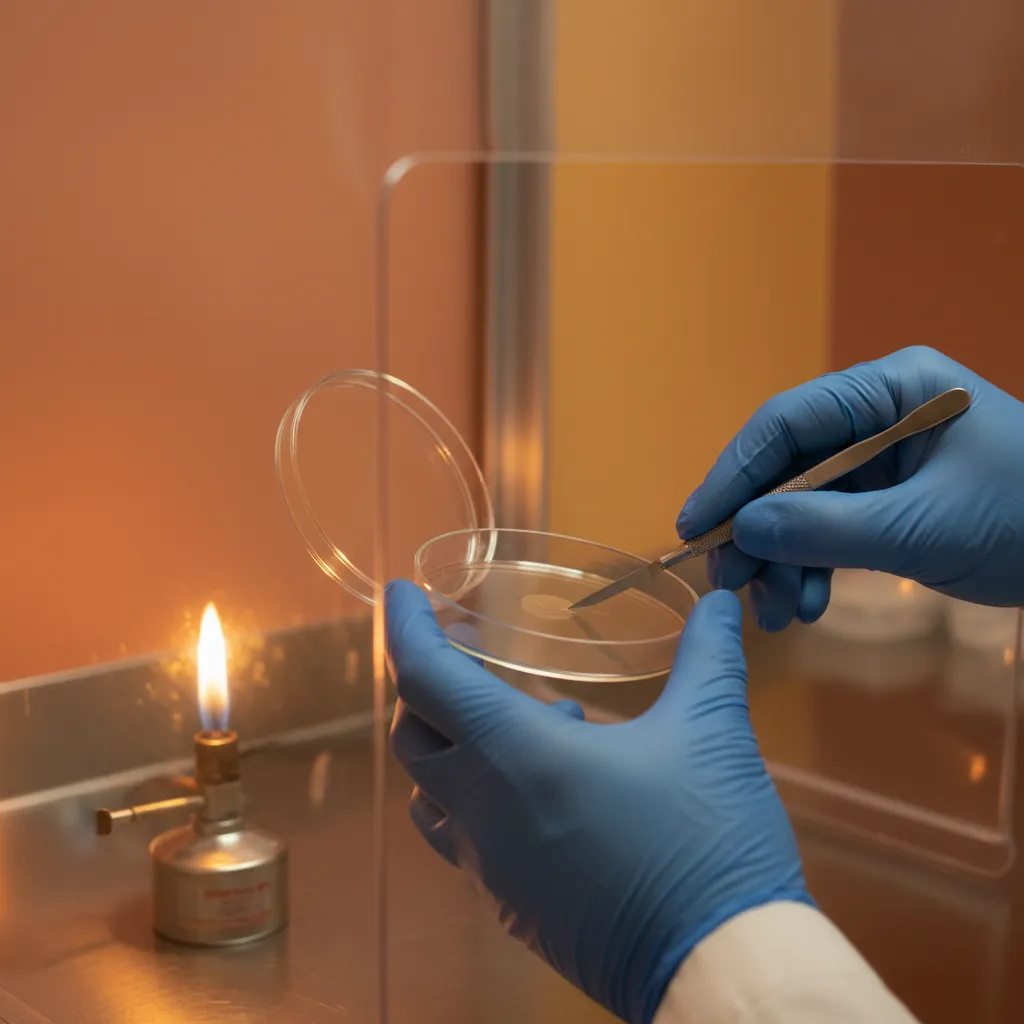
Working inside a still air box — gloved hands with agar plate and scalpel

If you want to grow mushrooms beyond the kit stage, you need a way to work with cultures without introducing contamination. That means agar plates, liquid culture syringes, grain jars, and spawn transfers. Every one of those tasks requires a clean environment where airborne contaminants are kept away from your work.
A still air box (SAB) is the simplest, cheapest solution. For under $15 and about 20 minutes of work, you can build one that will serve you for years. We've used SABs to do everything from pouring agar to inoculating dozens of grain jars, and our contamination rates stay consistently low when proper technique is followed.
This guide covers the full build, the technique that makes it work, and common mistakes that trip up beginners.
What Is a Still Air Box?
A still air box is exactly what it sounds like: a clear plastic tub turned upside down with two arm holes cut into one side. You reach inside through the holes, and the enclosed space prevents air currents from carrying contaminants onto your work.
Unlike a laminar flow hood, an SAB doesn't filter air. It works on a different principle entirely. In still air, contaminant particles settle downward due to gravity rather than floating around. As long as you don't create air currents inside the box (by moving too quickly, for example), those particles stay settled on the bottom and sides of the tub rather than landing on your agar plates or grain jars.
It's a low-tech approach, but it works remarkably well. Experienced growers routinely achieve contamination rates under 5-10% using a properly built and properly used SAB. That's good enough for any hobbyist and many small-scale commercial operations.
Why You Need One
If you're doing any of the following, you need either an SAB or a flow hood:
- Pouring or inoculating agar plates — agar is nutrient-rich and exposed. Without protection, mold spores land on it within seconds.
- Making or working with liquid culture — inoculating LC jars or drawing syringes from them exposes the liquid to open air.
- Inoculating grain jars — opening a sterilized grain jar outside of a clean environment is an invitation for Trichoderma and other contaminants.
- Doing grain-to-grain transfers — pouring colonized grain into fresh jars requires both jars to be open simultaneously.
- Cloning mushrooms — tissue culture involves cutting a small piece of mushroom and placing it on agar. Sterile conditions are essential.
You don't need an SAB for fruiting, harvesting, mixing substrate, or anything that happens after full colonization. The SAB is specifically for the vulnerable, sterile stages of cultivation.
Materials List
Here's everything you need. Total cost is typically under $15 CAD.
| Item | Estimated Cost | Notes |
|---|---|---|
| Clear plastic tub (64-106 qt / 60-100 L) | $8-12 | Sterilite or similar. Must be clear so you can see your work. Taller is better — you want room to maneuver inside. |
| Hole saw or soldering iron | $0-5 | A 10-13 cm (4-5 inch) hole saw attachment for a drill works best. A soldering iron or heated can also work. |
| Masking tape or marker | $0 | For marking hole positions. |
| Isopropyl alcohol (70%) | $3-5 | For sanitizing. You likely already have this. |
| Paper towels | $0 | For wiping down the interior. |
Optional but helpful:
- A small towel or mat to place inside the tub so items don't slide
- A spray bottle for the isopropyl alcohol
- Nitrile gloves
Step-by-Step Build

Step 1: Choose Your Tub
Look for a clear plastic storage tub in the 64-106 quart (60-100 litre) range. The Sterilite 106 qt tub from Canadian Tire or Walmart is a popular choice. You want it to be:
- Clear — you need to see what you're doing through the walls and lid
- Tall enough — at least 30 cm (12 inches) tall so you have room to work
- Wide enough — you'll have your arms inside, plus agar plates, a lighter, a scalpel, and whatever else you're working with
Step 2: Mark Your Arm Holes
Flip the tub upside down (the bottom facing up). The open side will face down toward your work surface when you use it.
On one of the long sides, mark two circles about 10-13 cm (4-5 inches) in diameter. Space them roughly shoulder-width apart, positioned in the lower half of the side wall. You want the holes low enough that your hands reach the bottom of the tub (which is now the top) comfortably.
Some growers put the holes on the bottom (now the top) of the tub instead. This works but makes it harder to see your work. Side-mounted holes are generally preferred.
Step 3: Cut the Holes
Hole saw method (recommended): Attach a 10-13 cm hole saw bit to your drill. Support the tub so the plastic doesn't flex too much, and drill through at moderate speed. The hole saw gives you a clean, round hole.
Soldering iron method: Heat the soldering iron and slowly melt through the plastic along your marked circle. This works but produces fumes — do it outside or in a well-ventilated area. The edges won't be as clean.
Hot can method: Heat an empty tin can on the stove and press it through the plastic. Crude but effective in a pinch.
Step 4: Smooth the Edges
Sand or file any rough edges around the holes. You'll be sliding your arms in and out, and sharp plastic edges will scratch you up. A few passes with fine-grit sandpaper is all it takes.
Step 5: Clean and Sanitize
Wipe down the entire interior of the tub with 70% isopropyl alcohol. Pay attention to corners and edges where dust accumulates. Let it air dry — 70% iso evaporates quickly.
That's it. Your SAB is built.
Isopropyl Alcohol 70% — 4 Litre Jug
The 4L jug is the best value for mushroom growers. 70% concentration is more effective at killing contaminants than 99% because the water content helps penetrate cell walls.
View on Amazon.ca →When you buy through our links, it supports our mycology research at no extra cost to you.
How to Use Your SAB: Proper Technique
Building the box is easy. Using it correctly is where most contamination happens. Here's the technique that keeps your work clean.
Setting Up Your Workspace
Choose a calm room. Turn off fans, close windows, shut off HVAC vents if possible. Any air current in the room is an air current inside your SAB. A bathroom or small room with the door closed works well.
Clean the room. Give the surfaces a quick wipe. Some growers spray Lysol in the room 15-20 minutes before working to knock airborne particles out of the air. Let it settle — don't work in a cloud of Lysol.
Prepare everything outside the box first. Get all your materials ready: agar plates, scalpel, lighter or alcohol lamp, parafilm, grain jars, syringes — whatever you're going to need. Arrange them on the table in front of you.
Wipe down the SAB interior with 70% iso and let it dry.
Wipe down every item that goes into the SAB. Jars, plates, tools, lighter, your gloved hands — everything gets a wipe or spray with iso.
Place items inside. Put everything into the SAB from the open bottom, then lower the tub over your workspace. Some growers prefer to put items in through the arm holes, but loading from underneath before flipping/lowering is easier.
Working Inside the SAB
This is where discipline matters.
Move slowly. Fast movements create air currents that stir up settled particles. Every reach, every pour, every movement should be deliberate and unhurried. Think of it like working underwater — smooth, controlled motions only.
Keep your arms still when not actively working. Your arms are pistons in the arm holes. Every time you move them, you pump air in and out of the box. Insert your arms, let the air settle for 30 seconds, then begin working.
Flame sterilize your scalpel and needle. Before every cut and every inoculation, heat your scalpel blade or needle in a flame until it glows red. Let it cool for a few seconds (don't blow on it — that defeats the purpose). This is non-negotiable, even inside the SAB.
Work near the bottom of the tub. Contaminants settle downward. The higher up in the SAB you work, the cleaner the air. Since the tub is flipped, the "top" of your workspace (the original bottom of the tub) is the cleanest zone.
Don't cough, sneeze, or breathe directly toward your work. Some growers wear a surgical mask. At minimum, turn your head away from the arm holes if you need to cough.
Open plates and jars for the minimum possible time. Have your inoculant ready, open the lid, do your work, close the lid. Seconds, not minutes.
Specific Tasks in the SAB
Agar work: Pour plates, inoculate with spore syringes, transfer cultures, and clone mushroom tissue inside the SAB. Have your parafilm strips pre-cut and ready. Seal each plate immediately after work.
Liquid culture inoculation: Shake your liquid culture jar, flame your needle, pierce the injection port, draw or inject, remove needle, done. Keep the jar upright the entire time.
Grain jar inoculation: Flame your needle, inject through the port or crack the lid just enough to insert the needle, inject 1-2 cc of liquid culture per jar, reseal immediately.
Common SAB Mistakes
We see these over and over, especially from growers who are getting consistent contamination:
Moving too fast. This is the number one mistake. Speed creates air currents. Slow down.
Not letting the air settle. After you put your arms in, wait. Thirty seconds minimum. The air you displaced needs to settle.
Working in a drafty room. The SAB doesn't seal airtight around your arms. If there's a draft in the room, it's getting into the box. Close windows, shut off fans, close the door.
Skipping flame sterilization. The scalpel touched the side of the tub? Flame it. The needle brushed your glove? Flame it. When in doubt, flame it.
Reaching in and out repeatedly. Every time you pull an arm out and put it back in, you create a piston effect that pushes and pulls air. Get everything you need inside the box before you start, and work through your batch without removing your arms.
Not wiping items down. That grain jar just came out of the pressure cooker and looks sterile, but the outside of the jar was exposed to room air. Wipe it with iso before it goes in the SAB.
Cluttered workspace. Too many items inside the SAB means more things to bump, more air currents, and less room to work. Only put in what you need for the current task.
SAB vs Flow Hood: A Quick Comparison
| Feature | Still Air Box | Laminar Flow Hood |
|---|---|---|
| Cost | $10-15 | $300-800+ |
| Setup time | 20 minutes | Hours (if building) |
| How it works | Gravity settles particles | HEPA filter removes particles |
| Contamination rate | 5-10% (with good technique) | 1-2% |
| Best for | Hobbyists, small-batch work | Scaling up, high-volume |
| Portability | Easy to store anywhere | Bulky, semi-permanent |
| Learning curve | Technique-dependent | More forgiving |
For most home growers, an SAB is all you'll ever need. If you're making dozens of plates or jars per session, or if you're starting to scale toward a commercial operation, a flow hood becomes worth the investment. We have a full breakdown in our flow hood vs SAB comparison.
Tips for Better SAB Results
Use an alcohol lamp instead of a lighter. An alcohol lamp provides a continuous flame and an updraft of warm air above it. That rising air column creates a small sterile zone. Position your work near (but not directly over) the flame for an extra layer of protection. You can make an alcohol lamp from a small glass jar, a cotton wick, and 70% iso or high-proof alcohol.
Dampen the inside walls. A light mist of water on the inside walls of the SAB helps trap airborne particles on the plastic surface rather than letting them float.
Work at night. There are fewer airborne contaminants circulating when the house is quiet — no one walking around, no doors opening, no cooking.
Batch your work. Rather than opening and closing the SAB repeatedly over several days, do all your agar transfers, inoculations, and culture work in a single session.
Keep a clean tub. After each session, wipe the SAB down with iso and store it inverted (holes facing down) to keep dust out.
What You Can Do With an SAB
Once you have a working SAB, the entire upstream side of mushroom cultivation opens up to you:
- Pour and inoculate agar plates to isolate clean cultures
- Make and inoculate liquid culture
- Clone your best mushrooms onto agar
- Inoculate grain spawn jars and bags
- Do grain-to-grain transfers to multiply your spawn
- Work with spore prints and spore syringes
A $15 tub with two holes in it is genuinely all that stands between you and self-sufficient mushroom cultivation. Build one this weekend, grab some agar plates from our shop, and start learning. The technique takes a few sessions to dial in, but once you've got it, you'll wonder why you ever bought pre-made syringes.
Need help with your grow? Dr. MycoThumb is our free AI growing assistant — ask about substrates, contamination, fruiting conditions, or any cultivation question. Available 24/7 in the chat bubble at the bottom-right of every page.
